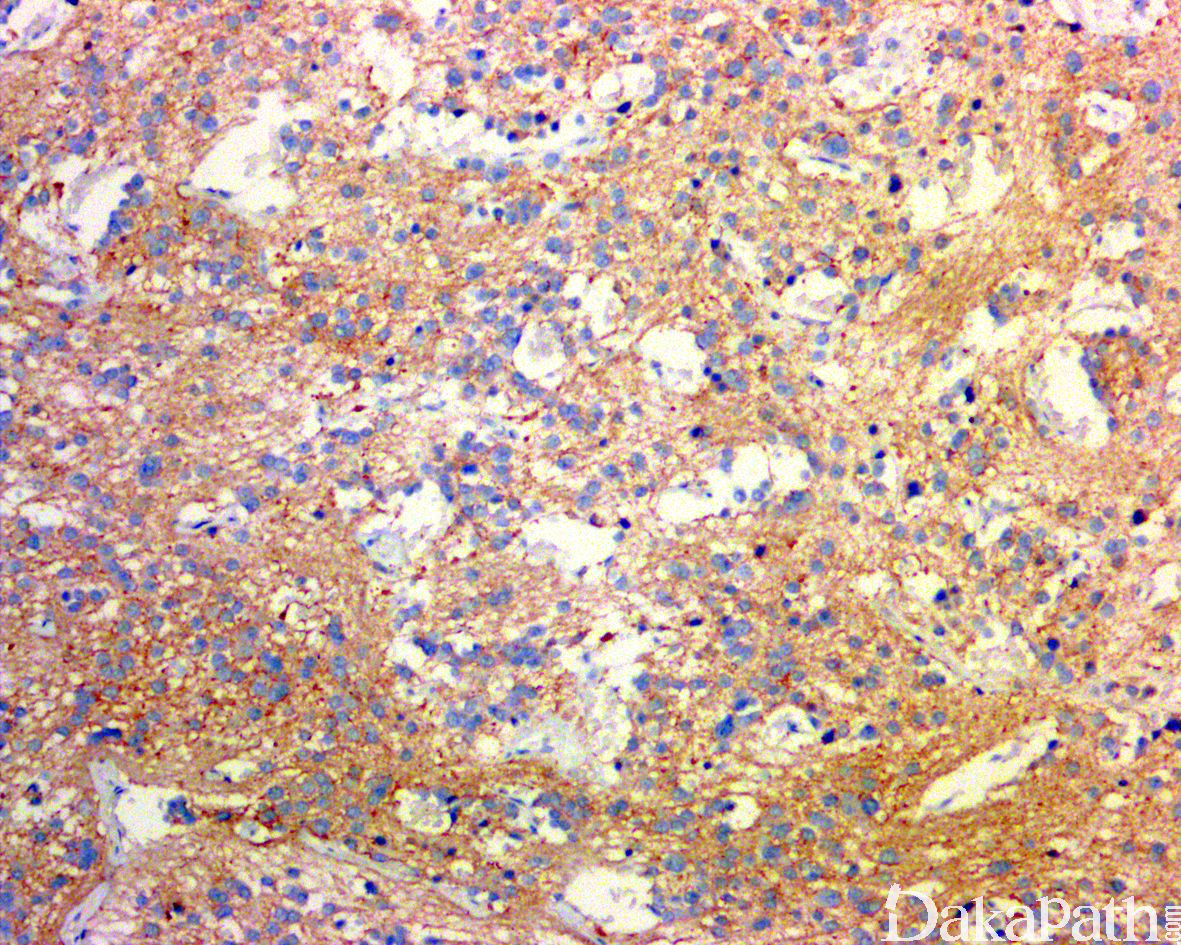

神经母细胞瘤
Neuroblastoma,NB
发病部位: 腹膜后、肾上腺髓质、腹腔、胸腔、纵隔、盆腔、骶部、颈部
诊断要点:
属于肾上腺髓质和交感神经起源的胚胎性肿瘤,多为散发性,家族性亦可存在,多与 ALK 活化突变相关;神经母细胞瘤多发生于婴幼儿,40%患者在 1 岁以内,90%在 5 岁以内(中位发病年龄 18 个月),偶见于成人,可发生在自颅底至盆腔的任何部位,肾上腺和肾上腺外的发生比例约 1.5-2:1,约 1%的肿瘤原发部位可能无法明确;肿瘤直径从 1cm 至充满整个腹腔不等,切面常呈分叶状,质地柔软,鱼肉状,常见出血、坏死、囊性变和钙化;后腹膜肾上腺之外的较大的肿瘤常常累及临近器官(如肝脏、胰腺等)
组织学上可分为未分化、低分化和分化型三种亚型:
未分化型:
由巢状或小叶状分布的小至中等大神经母细胞所组成,巢或小叶之间为纤细的纤维血管性间隔;
瘤细胞小而一致,胞浆稀少,染色质细腻,核仁不明显,核分裂象较活跃;神经节细胞分化< 5%,神经节细胞分化定义为瘤细胞的胞体和胞核同时增大,细胞的直径 2 倍或以上于核的直径(诊断神经节细胞分化所必须),可见丰富的双嗜性胞浆,核偏位伴有空泡状染色质以及明显的核仁;部分细胞表现为未分化神经母细胞瘤和成熟的神经节细胞之间的过渡状态,表现为瘤细胞核轻度增大伴有开放的染色质和明显的核仁;
肿瘤内的间质无或罕见神经纤维网(神经毡);
常见出血和坏死,不应将坏死误认为是神经毡结构;
低分化型:
在未分化型的神经母细胞形态学基础上,在局灶区域或明显可见神经纤维网(神经毡)和(或)Homer-Wright 菊形团(约 30%):1 层或数层神经母细胞围绕中央的神经毡性间质呈放射状排列;
瘤细胞核染色质呈粉尘状或点彩状,神经节细胞分化< 5%;
偶见体积较大、异型性较明显的瘤细胞伴有开放的染色质和显著的核仁,少数可表现为 Rhabdoid 的胞浆特征;
分化型:
肿瘤间质内含有大量的神经纤维网(神经毡),神经节细胞分化超过 5%;
纤维血管间质或间隔内常见梭形施万细胞性间质,但< 50%肿瘤比例,多位于肿瘤的周边区域;
少数病例瘤细胞具有明显的多形性,核深染、不规则,也称间变性神经母细胞瘤(anaplastic neuroblastoma);
另有一部分病例富于血管,瘤细胞的胞质内含有糖原,也称血管瘤样神经母细胞瘤(angiomatoid neuroblastoma);
少数肿瘤表现为胞浆较丰富伴有空泡状染色质和明显的 1 到 4 个核仁绕以核仁周空晕,称之为大细胞神经母细胞瘤。
免疫组织化学染色:
NSE 弥漫强阳性、NF、Leu-7. PHXO2B 等阳性;亦常见 synaptophysin、chromogranin、CD56 及 PGP9.5 阳性。未分化的神经母细胞弥漫表达 cyclind1 而神经节细胞不表达,GFAP、MBP、CD99 和 β-2 微球蛋白均为阴性。施万间质呈 S100 阳性。与 N-MYC 扩增相关的肿瘤可过表达 N-myc。
分子标记:
N-MYC 扩增,1p 缺失,17q 获得等
鉴别诊断:
胚胎性横纹肌肉瘤 :可见带状、蝌蚪状细胞及大多边形的横纹肌母细胞;免疫组织化学染色 desmin、MyoD1. MSA 和 myogenin 等肌源性标记物阳性。
骨外尤文肉瘤 / :瘤细胞核规则,染色质细致,胞质内多含有糖原;多无神经纤维网,菊形团结构稀少或无;瘤细胞 CD99 阳性,FISH 检测显示 EWSR1 基因断裂;
淋巴母细胞性淋巴瘤:CD45+,tdt+, CGA 和 SYN 阴性;
NUT 中线癌:弥漫表达角蛋白和 NUT 蛋白,遗传学上存在 t(15,19)易位导致 BRD4-NUT 基因重排;
转移性髓母细胞瘤:髓母细胞瘤和神经母细胞瘤均可转移至骨,神经母细胞瘤亦可转移至脑,两者在组织学尚存在明显的相似性,髓母细胞瘤年龄较神经母细胞瘤的年纪一般大 5-10 岁,另外需要结合病史和影像学特征;
促结缔组织增生性小圆细胞肿瘤:desmin+, NSE+, ck+, 遗传学上存在 EWSR1-WT1 基因融合。
治疗:
低度危险组:手术切除为主;中度危险组:手术伴化疗和/或放疗;高度危险组:多药物化疗伴手术和放疗
病例报道:
Adult** neuroblastoma in the retroperitoneum: A case report.
Wu XL, Dai YJ, Sun GY, Wang LK, Han L, Qu M, Liu B, Xue J.
Medicine (Baltimore). 2018 Dec;97(51):e13750. doi: 10.1097/MD.0000000000013750. 参考文献:
Shimada H, Ambros IM, Dehner LP, et al. Terminology and morphologic criteria of neuroblastic tumors. R.ecmmru:ndations by the International Neuroblastoma Pathology Committee. Cancer 1999;86: 349-363. Tornoczky T, Kalman E, Kajar PG, et al. Large cell neuroblasoma. A distinct phenotype of neuroadenoma with aggressive clinical behavior. Cancer 2004;100:390-397. Magro G , Salvatorelli L , Alaggio R , et al. Diagnostic Utility of Cyclin D1 in the Diagnosis of Small Round Blue Cell Tumors in Children and Adolescents[J]. Human Pathology, 2016:S0046817716302647.